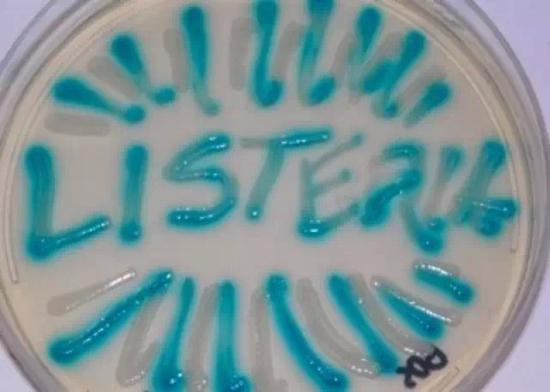
谨防冰箱里的“杀手”:李斯特菌

首页>寻医·问药>名家健坛名家健坛
谨防冰箱里的“杀手”:李斯特菌
作者:陕西省人民医院主任药师 李巧如
盛夏季节,冰箱里的冷饮冷食无疑就会成为大多数人钟情的消暑食品。但是,在人们尽情享受美食的时候,有一种细菌同样非常喜欢冰箱的温度,会在人们毫无知觉的情况下,对人体健康造成危害,这就是李斯特菌。
李斯特菌是一种需氧兼性厌氧革兰氏阳性杆菌,主要以食物为传染媒介,是最致命的食源性病原体之一。李斯特菌在自然界中分布较为广泛,在腐烂的植物、土壤、动物粪便、污水、饲料和水中均可找到其踪迹。它在5℃~45℃都能生存,最容易污染的食品为乳和乳制品、肉和肉制品、蔬菜、沙拉、海产品和冰淇淋等,尤其是冰箱中保存时间过长的乳制品、肉制品,是最常见的李斯特菌的食物传染媒介。
因为西方人喜食冷饮,此菌在西方存在爆发流行现象。现如今,随着我们的饮食习惯,尤其是年轻人的饮食习惯的逐渐西化,此菌的感染率已呈现出逐年上升趋势,希望大家能予以重视。
李斯特菌主要易感人群为孕妇、新生儿以及免疫功能低下者。感染此菌后的3天~70天产生临床表现。健康者临床表现和流感相似,轻者为腹泻、腹痛、发热,重者可导致败血症、脑膜炎。孕妇感染李斯特菌后,细菌能够经血液进入胎盘中,孕妇可出现发热、呕吐、出血性皮疹、化脓性结膜炎、昏迷以及流产,甚至发生死胎等后果。幸存的新生儿则易因患脑膜炎,导致智力缺陷或死亡。
人们一旦感染了李斯特菌,虽然后果比较严重,但其感染可防可控,且治疗方法简单有效。我们在平时生活中注意饮食卫生即可有效预防。
具体做法是:
1. 大家在冰箱储存食物时应做到生熟分开并保持清洁。
2. 在烹调食物时,要确保烧熟煮透。
3. 冰箱里的剩菜,应将其热透才能吃。
4. 不要喝未经巴氏消毒和彻底煮开的生奶。
5. 不要吃没有经过彻底加热的肉、火腿、卤肉等熟食。即使是有密封包装或有冷藏存放条件的食品。
6. 应对家中冰箱里的食物定期进行清理,并定期清洁冰箱。
编辑:赵彦
关键词:冰箱杀手 李斯特菌


中国制造助力孟加拉国首条河底隧道项目
澳大利亚猪肉产业协会官员看好进博会机遇
联合国官员说叙利亚约1170万人需要人道主义援助
伊朗外长扎里夫宣布辞职
中国南极中山站迎来建站30周年
联合国特使赴也门斡旋荷台达撤军事宜
以色列前能源部长因从事间谍活动被判11年监禁
故宫博物院建院94年来首开夜场举办“灯会”
法蒂玛·马合木提
王召明
王霞
辜胜阻
聂震宁
钱学明
孟青录
郭晋云
许进
李健
覺醒法師
吕凤鼎
贺铿
金曼
黄维义
关牧村
陈华
陈景秋
秦百兰
张自立
郭松海
李兰
房兴耀
池慧
柳斌杰
曹义孙
毛新宇
詹国枢
朱永新
张晓梅
焦加良
张连起
龙墨
王名
何水法
李延生
巩汉林
李胜素
施杰
王亚非
艾克拜尔·米吉提
姚爱兴
贾宝兰
谢卫
汤素兰
黄信阳
张其成
潘鲁生
冯丹藜
艾克拜尔·米吉提
袁熙坤
毛新宇
学诚法师
宗立成
梁凤仪
施 杰
张晓梅


